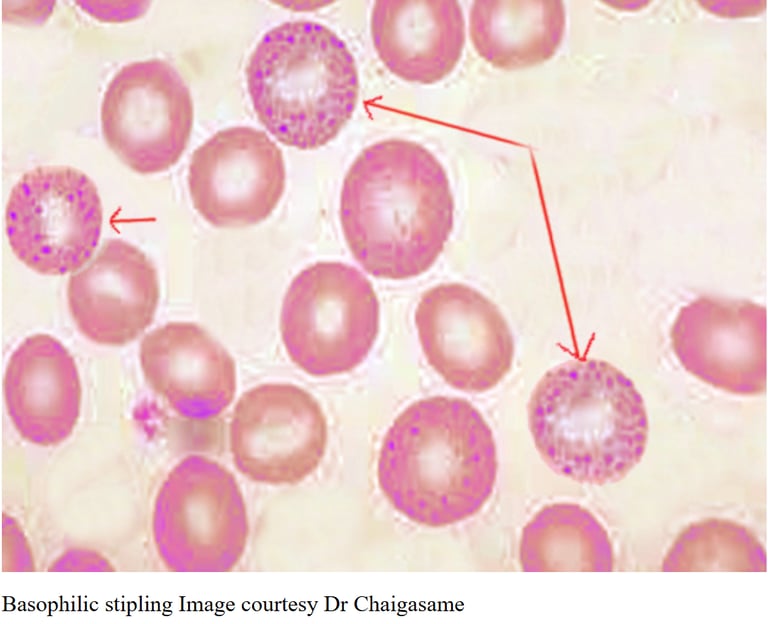
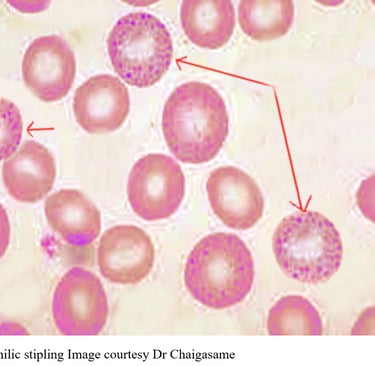

"Bitkisel Kozmetik"
Kurşun Zehirlenmesi
Kronik Kabızlıkta "Görünmeyen Kelepçe"nin Analizi
Dr. Aleksi
1/5/20265 min oku


Kronik kabızlık ve "açıklanamayan karın ağrısı" (İrritabl Bağırsak Sendromu - IBS etiketi yapıştırılıp geçilen vakalar), DAD projesinin doğru tanı koyarak çözümlediği "Tanısal Gürültü" alanlarından biridir.
Çoğu doktor, kurşun zehirlenmesinde ortaya çıkan kabızlık durumuna -eğer Kurşun zehirlenmesi tanısını atlamadıysa- "Kurşun bağırsak hareketini yavaşlatır" deyip geçer. Ama nasıl? Kurşun (Pb) hangi reseptörü kilitliyor? Neden ağrı yapıyor?
İşte "Gözden Kaçan'' kabızlığı olan sancılı vakamız:
Vaka: Bağırsak Felci ve Kurşun Koliği
DAD Protokolü: Kronik Kabızlıkta "Görünmeyen Kelepçe"nin Analizi
Bir Acil servisi hayal edin. Orta yaşlı bir hasta, karnını tutarak kıvranıyor. Ağrı o kadar şiddetli ki yatakta dönüp duruyor. Cerrah karnına bastırıyor; beklenenin aksine hasta rahatlıyor ve karın "yumuşak". Akut apandisit değil, peritonit değil. Peki bu adam neden bağırıyor? Cevap, yıllar önce soluduğu tozda veya içtiği suda gizli.)
Modern tıp, kronik kabızlığı genellikle "lif eksikliği" veya "stres" olarak etiketler. Ancak biyokimyasal dedektiflik (DAD) yaptığımızda, kurşun (Pb) zehirlenmesinin bağırsak sinir sistemine (Enterik Sinir Sistemi) yaptığı sabotajı görürüz.
Önce,' modern' tıbbın yüzeysel bıraktığı boşlukları dolduralım (Gap Analizi):
Doktorlar; "Kurşun motiliteyi bozar" diyor ama ALA (Aminolevulinik Asit) birikiminden bahsetmiyor. Oysa karın ağrısının ana sebebi kurşun değil, kurşunun yarattığı enzim blokajı sonucu biriken ALA molekülüdür. Ayrıca tanıda "Basofilik Noktalanma" (Basophilic Stippling) gibi kan yayması bulgularını ve kemik depolarını incelemezsek bunları atlarız.
Doktor Aleksi Diagnostik (DAD) projemizde ise hücrenin derinliklerine iniyoruz.
BÖLÜM 1: Mekanizma - Bağırsak Neden Durur?
Kurşun, vücuda girdiğinde sadece bir "toksin" olarak dolaşmaz; bir "Kalsiyum Taklitçisi" olarak davranır.
Kalsiyum Kanal Blokajı (Felç): Bağırsak düz kaslarının kasılması (peristaltizm) için kalsiyumun hücre içine girmesi gerekir. Kurşun, kalsiyum kanallarına oturur ama kapıyı açmaz. Kalsiyum giremeyince kas kasılamaz. Sonuç: Paralitik İleus benzeri inatçı bir kabızlık.
ALA Toksisitesi (Ağrının Kaynağı): Kurşun, hemoglobin üretimindeki ALA-Dehidrataz enzimini bloklar. Bu blokaj sonucu Aminolevulinik Asit (ALA) birikir.
Kritik Bilgi: ALA, tıpkı Akut Porfiri hastalığında olduğu gibi, doğrudan bağırsak sinirlerine toksiktir. O meşhur "Kurşun Koliği"nin sebebi, sinirlerin asit banyosunda yanmasıdır.
Hücresel Enerji Krizi: Kurşun, ATP (enerji) üretimini bozar. Enerjisi olmayan bağırsak hücresi, atıkları itecek gücü bulamaz.
BÖLÜM 2: Klinik Tablo ve "Kurşun Koliği" (Lead Colic)
Bu tabloyu diğer karın ağrılarından ayıran çok spesifik bir Bayesyen Triad vardır:
Paradoksal Ağrı (LR+ Yüksek): Hasta şiddetli ağrı çeker (doğum sancısı gibi), ancak karın muayenesinde "Tahta Karın" (sertlik) yoktur. Hatta hasta karnına bastırılmasından hoşlanır (derin basınç ağrıyı hafifletir). Peritonitte ise hasta dokundurtmaz. Bu ayrım hayati öneme sahiptir.
İnatçı Kabızlık (Saturnine Gout): Bu kabızlık lifle, suyla düzelmez. Çünkü sorun mekanik değil, nörolojiktir.
Burton Çizgisi (Görsel Kanıt): Diş etlerinde, diş köklerine yakın yerde mavi-siyah ince bir çizgi. Bu, ağızdaki bakterilerin ürettiği sülfürün, dokudaki kurşunla birleşip "Kurşun Sülfür" oluşturmasıdır.
BÖLÜM 3: Tanıda Bayesyen Veriler ve Test Stratejisi
Bir hastaya "İrritabl Bağırsak" (IBS) demeden önce şu olasılıkları hesaplamalıyız:
A. Laboratuvar Kanıtları (Evidence)
Kan Kurşun Düzeyi (BLL):
Duyarlılık: %85 (Akut maruziyette).
Kısıtlılık: Kronik vakalarda kurşun kanda durmaz, kemiğe saklanır. Kan "normal" çıkabilir (Yalancı Negatif).
Periferik Yayma (Basofilik Noktalanma):
Mikroskopta eritrositlerin içinde "karabiber serpilmiş gibi" mavi noktalar görülür.
LR+ (Pozitif Olasılık Oranı): 15-20. (Yani bu bulgu varsa, kurşun zehirlenmesi olasılığı 20 kat artar. Çok güçlü bir kanıttır).
İdrar ALA/PBG: İdrarda ALA artışı, karın ağrısının kurşuna bağlı olduğunu doğrular.
B. Bayesyen Algoritma
Ön Olasılık (Prior): Hasta eski bir evde yaşıyor (eski borular/boya) veya sanayide çalışıyor + Kronik Kabızlık + Anemi var. -> %30 Şüphe.
Test 1: Karın muayenesi yumuşak ama ağrılı. -> Olasılık %50'ye çıkar.
Test 2: Diş etinde mavi çizgi veya yaymada noktalı eritrosit. -> Olasılık %95'e çıkar (Tedavi Eşiği aşılır).
BÖLÜM 4: Modern ve Fonksiyonel Tedavi Protokolü
Genel olarak doktorlar kurşun zehirlenmesinin tedavisi için "Şelasyon yapılmalı" der. Bu doğrudur ama eksik bilgidir: DAD protokolünde ise strateji şöyledir: "Önce Kanalı Aç, Sonra Boşalt." Kabız olan hastaya şelasyon yapılmaz! Toksin bağırsaktan geri emilir (Enterohepatik döngü).
Adım 1: Mekanik Tahliye (Önce Kabızlığı Çöz)
Kurşun bağırsakları durdurduğu için, önce magnezyum sitrat veya lavman ile yol açılmalıdır. Toksin dolu dışkı atılmalıdır.
Adım 2: Şelasyon (Kimyasal Kıskaç)
Modern Ajanlar:
CaNa2EDTA: Damardan verilir. Kurşunu kemikten söker.
DMSA (Oral): Daha güvenlidir, cıva ve kurşunu bağlar.
Dikkat: Şelasyon sırasında böbrekler korunmalıdır (Bol su).
Adım 3: Doğal Destekler ve Metabolitler
Modifiye Turunçgil Pektini (MCP): DAD projesinin favori doğal şelatörüdür. Kana geçer, kurşunu nazikçe bağlar ve idrarla attırır. Yan etkisi yok denecek kadar azdır.
Sarımsak (Allisin/Sülfür): Sülfür, kurşunun baş düşmanıdır. Doğal bir bağlayıcıdır. Çalışmalar, sarımsağın hafif-orta düzey vakalarda D-Penisilamin kadar etkili olabileceğini göstermiştir.
B1 Vitamini (Tiamin): Kurşunun biriktirdiği toksik ALA'nın etkilerini azaltır ve sinir iyileşmesini hızlandırır.
Kalsiyum ve Demir: Vücudu "gerçek" minerallere boğarak, kurşunun emilmesini (yarışmalı inhibisyon) engelleriz.
BÖLÜM 5: Prognoz ve Son Söz
Prognoz: Erken tanıda (nörolojik hasar kalıcı olmadan) bağırsak fonksiyonları tamamen döner. Ağrı, şelasyonun başlamasından 48 saat sonra bıçak gibi kesilir.
Doktor Aleksi Diagnostik (DAD) Analizinin Özeti: Kronik kabızlığı olan, hafif anemik ve agresif/sinirli bir hasta gördüğünde; reçeteye hemen laksatif yazma. Önce diş etlerine bak, sonra mesleğini sor. Eğer "eski ev tadilatı yapıyorum" veya "akü fabrikasındayım" diyorsa; o karın ağrısı bağırsaktan değil, moleküler bir sabotajdan geliyordur.
Kurşun, sessizce bağırsağı durdurur; bizim işimiz o sessizliği kanıt (Bayesyen analiz) ile bozmaktır.

Youtube videosunu ana dilinde alt yazıyla izlemek isteyenler videonun altındaki alt yazı seçeneğini ve ayarlardan kendi ana dilini seçerek izleyebilirler.
İletişim
Bize ulaşmak için aşağıdaki bilgileri kullanın.
Hİzmetler
Tıbbi Sorumluluk Reddi (Disclaimer):
Bu web sitesinde sunulan tüm içerikler yalnızca bilgilendirme amacı taşır. Sunulan bilgiler, profesyonel tıbbi tanı, tedavi ya da tavsiye yerine geçmez. Web sitesinde yer alan sağlık bilgilerinin, tıbbi karar verme sürecinizde tek başına kullanılmaması gerekir. Herhangi bir sağlık sorununuzda, şikâyetinizde ya da tedavi ihtiyacınızda mutlaka bir doktor veya ilgili uzman sağlık profesyoneline danışınız. Bu sitede yer alan bilgilerin kullanımından doğabilecek herhangi bir doğrudan ya da dolaylı zarardan dolayı site sahibi veya yazarlar sorumluluk kabul etmez.
© 2025 İlkiz Açıkalın
